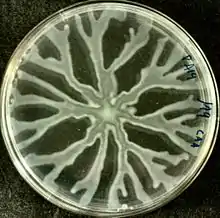

Social motility
Social motility describes the motile movement of groups of cells that communicate with each other to coordinate movement based on external stimuli. There are multiple varieties of each kingdom that express social motility that provides a unique evolutionary advantages that other species do not possess. This has made them lethal killers such as African trypanosomiasis,[1] or Myxobacteria.[2] These evolutionary advantages have proven to increase survival rate among socially motile bacteria whether it be the ability to evade predators[3] or communication within a swarm to form spores for long term hibernation in times of low nutrients or toxic environments.[4]
.jpg.webp)
Communication
Bacterial cells are able to communicate with one another through the use of chemical messengers. These chemical messengers are passed from one cell to the next to control factors such as virulence, growth and nutrient conditions, etc. As first discovered in plants, diffusible signal factors (DSFs) have been found in bacteria such as Burkholderia cenocepacia and Pseudomonas aeruginosa.[5] When individual cells are stimulated by DSF, it causes them to release their own DSF to spread the signal further and also to generate a response to the DSF often seen as growth, movement, or sporulation in unfavorable growth conditions. Via these chemical messengers, swarms of bacteria are able to increase the rate of survival compared to single cell bacteria on their own.
Benefits
Predation
Traveling in groups, often referred to as swarms, is beneficial to the organism. For instance, when Myxobacteria swarms and feeds on prey, all individual cells release hydrolytic enzymes. This abundance of metabolic enzymes allows the swarm to easily degrade and engulf the prey.[2] Interactions between separate species of organisms in a given environment is very common. Production of toxins, usually in the form of antibodies, allows for cells to ward off other organisms from infringing on their niche. Similar to the combined release of degrading enzymes, antibodies allow for a colony of bacteria to fight off surrounding organisms in the same habitat.
Survival
Increased survival rates are seen in motile bacteria. This can be attributed to factors such as Chemotaxis, bacteria's ability to sense and migrate towards nutrients. The Chemotaxis mechanism can be amplified by social motility to alert all cells in the cluster of bacteria to move towards nutrients. The same is true of any toxic substances and the avoidance of that toxic environment by motile bacteria.
Examples
Swarming
Swarming motility is the coordinated movement of bacteria along a solid/semisolid surface. Swarming motility can usually be observed in a laboratory setting, depending on the conditions of media nutrient concentration, and the viscosity of the surface of the media. More information on swarming motility can be found here.[6]
Gliding
Mechanisms that drive gliding motility are still unknown. However, despite lacking flagella, pili, and fimbriae, bacteria such as Myxococcus xanthus are able to move across surfaces in a gliding motion. Close studies of the myxococcus xanthus has proposed ideas of how the bacteria are able to move across surfaces.[7] Inner membrane protein complexes, such as AgmU, propel the organism forward as these protein complexes function similar to the flagella complex of other motile organisms. These protein complexes, powered by a proton motive force, rotate within the membrane allowing cells to glide over surfaces.
Twitching
Built for use by many in the bacterial world, Twitching Motility is an important tool that bacteria use to move across moist surfaces. Twitching Motility uses a type IV pili that extends, tethers to a surface, and then pulls the bacteria forward. This allows for quicker growth across biofilms and fruiting bodies. Type IV pili is run by over forty genes that regulate this type of motility.[8] Myxococcus xanthus ability to use gliding motility to move is very similar to Pseudomonas aeruginosa twitching motility.[1] Pseudomonas aeruginosa is a very motile bacteria species but it has some drawbacks, in one experiment a team of researchers discovered that if they put pressure on colonies that exhibited the quickest motility it led to decreased production of biofilm formation but drastically increased rates of motility. They then compared their quickest strain to wild type species to see if there is a need for higher rates of motility in the environment but none came close. Overall increasing speeds did not increase the chance for survival in the long run.[9]
References
- Oberholzer, Michael; Lopez, Miguel A.; McLelland, Bryce T.; Hill, Kent L. (2010-01-29). "Social Motility in African Trypanosomes". PLOS Pathogens. 6 (1): e1000739. doi:10.1371/journal.ppat.1000739. ISSN 1553-7374. PMC 2813273. PMID 20126443.
- Muñoz-Dorado, José; Marcos-Torres, Francisco J.; García-Bravo, Elena; Moraleda-Muñoz, Aurelio; Pérez, Juana (2016). "Myxobacteria: Moving, Killing, Feeding, and Surviving Together". Frontiers in Microbiology. 7: 781. doi:10.3389/fmicb.2016.00781. ISSN 1664-302X. PMC 4880591. PMID 27303375.
- Matz, Carsten; Jürgens, Klaus (2005-02-01). "High Motility Reduces Grazing Mortality of Planktonic Bacteria". Applied and Environmental Microbiology. 71 (2): 921–929. Bibcode:2005ApEnM..71..921M. doi:10.1128/AEM.71.2.921-929.2005. ISSN 0099-2240. PMC 546711. PMID 15691949.
- Nickerson, Kenneth W.; Bulla, Lee A. (1974-07-01). "Physiology of Sporeforming Bacteria Associated with Insects: Minimal Nutritional Requirements for Growth, Sporulation, and Parasporal Crystal Formation of Bacillus thuringiensis". Applied Microbiology. 28 (1): 124–128. doi:10.1128/am.28.1.124-128.1974. ISSN 0003-6919. PMC 186607. PMID 4844274.
- Ryan, Robert P.; Dow, J. Maxwell (2011-03-01). "Communication with a growing family: diffusible signal factor (DSF) signaling in bacteria". Trends in Microbiology. 19 (3): 145–152. doi:10.1016/j.tim.2010.12.003. ISSN 0966-842X. PMID 21227698.
- "Swarming motility", Wikipedia, 2019-10-05, retrieved 2019-10-10
- Nan, Beiyan; Chen, Jing; Neu, John C.; Berry, Richard M.; Oster, George; Zusman, David R. (2011-02-08). "Myxobacteria gliding motility requires cytoskeleton rotation powered by proton motive force". Proceedings of the National Academy of Sciences. 108 (6): 2498–2503. Bibcode:2011PNAS..108.2498N. doi:10.1073/pnas.1018556108. ISSN 0027-8424. PMC 3038734. PMID 21248229.
- Mattick, John S. (2002). "Type IV pili and twitching motility". Annual Review of Microbiology. 56: 289–314. doi:10.1146/annurev.micro.56.012302.160938. ISSN 0066-4227. PMID 12142488.
- van Ditmarsch, Dave; Boyle, Kerry E.; Sakhtah, Hassan; Oyler, Jennifer E.; Nadell, Carey D.; Déziel, Éric; Dietrich, Lars E. P.; Xavier, Joao B. (2013-08-29). "Convergent evolution of hyperswarming leads to impaired biofilm formation in pathogenic bacteria". Cell Reports. 4 (4): 697–708. doi:10.1016/j.celrep.2013.07.026. ISSN 2211-1247. PMC 3770465. PMID 23954787.